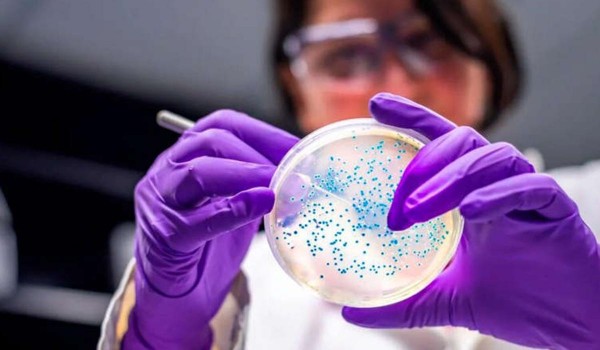
Descubrieron el mecanismo por el cual algunas bacterias sobreviven a los antibi�ticos

Jueves 23 de Diciembre 2021
AstraZeneca anunció que una tercera dosis de su vacuna aumenta el nivel de anticuerpos contra Ómicron
El laboratorio citó un estudio clínico reciente en el que se comprobó que su fórmula neutraliza a la nueva cepa del coronavirus
Miércoles 22 de Diciembre 2021
La OMS no recomienda la vacunación general anticovid entre niños y adolescentes
La organización argumenta que la tasa de casos graves de la enfermedad en estos grupos es baja.
Miércoles 22 de Diciembre 2021
Marta Cohen explicó cuáles fueron los errores que provocaron el aumento exponencial de contagios
La médica patóloga y pediatra argentina que reside en el Reino Unido planteó que en el mundo hubo un “mensaje equivocado” de llamar a la “vida normal” y a dejar de lado los barbijos; también habló de la inequidad de las vacunas a nivel internacional
Lunes 20 de Diciembre 2021
Los casos de COVID-19 aumentaron un 75% en una semana y la tasa de positividad superó la recomendada por la OMS
El salto del número de positivos fue de 75,78%. Los enfermos graves habían aumentado un 31% hasta la semana última, pero sólo estaba ocupado un 5,75% del sistema
Lunes 20 de Diciembre 2021
Se suma evidencia: qué se sabe hasta ahora sobre la efectividad de las vacunas contra ómicron
La información preliminar sugiere que la mayoría de los inmunizantes existentes contra Covid no evitarían el contagio
Lunes 20 de Diciembre 2021
Moderna indicó que el refuerzo de su vacuna protege contra la variante Ómicron con una fuerte alza de anticuerpos
La firma presentó los resultados de las pruebas de laboratorio y también indicó que si la tercera dosis se duplica en microgramos, el nivel de defensas inmunitarias se multiplica por 80
Viernes 17 de Diciembre 2021
Los CDC recomiendan las vacunas Pfizer, Moderna sobre Johnson & Johnson, citando un problema poco común de coágulos de sangre
Se han confirmado nueve muertes, varias docenas de casos, en relación con la vacuna.
Sábado 11 de Diciembre 2021
La neutralización de los anticuerpos de vacunados baja frente a la variante Ómicron
Especialistas consultados por Télam coincidieron en que "al no haber datos epidemiológicos aún disponibles es imposible determinar si las vacunas protegerán contra las formas severas y fallecimiento frente a esta nueva variante".
Viernes 10 de Diciembre 2021
El creador de la vacuna de Biontech y Pfizer aconseja el “refuerzo relámpago”: una dosis extra después de los tres meses
Ugur Sahin sostuvo también que dos aplicaciones “no son esquema completo con protección suficiente” y consideró que aún hay que analizar si será necesaria una nueva fórmula contra la variante Ómicron
Jueves 09 de Diciembre 2021
La Organización Mundial de la Salud dijo que la inmunidad de las vacunas contra el COVID-19 dura hasta seis meses
OMS - La directora del Departamento de Inmunización del organismo, Kate O’Brien, explicó que llegaron a esa conclusión tras el análisis de los datos disponibles previos al surgimiento de la variante Ómicron
Miércoles 08 de Diciembre 2021
Pfizer anunció que la tercera dosis de su vacuna aumenta 25 veces la protección contra la variante Ómicron de coronavirus
El laboratorio comunicó los resultados de las primeras pruebas contra la nueva cepa, y advirtió que sólo dos dosis pueden ser menos eficaces
Miércoles 08 de Diciembre 2021
Para la OMS no hay pruebas de que Ómicron pueda causar una enfermedad más grave de Covid-19
Un alto funcionario del organización afirmó que no hay razones "para dudar" de la eficacia de las vacunas contra la nueva cepa.
Miércoles 08 de Diciembre 2021
La vacuna de Pfizer protege parcialmente contra Ómicron
La capacidad de Ómicron para evadir la inmunidad inducida por vacunas e infecciones es “sólida pero no completa”, dijo el director de investigación de un laboratorio en el Instituto de Investigaciones Sanitarias de África en Sudáfrica.
Martes 07 de Diciembre 2021
Tras la suba de contagios, la Ciudad de Buenos Aires y Tucumán pasaron a un estado de alerta sanitario
El promedio en la Capital aumentó un 75%, mientras que en la provincia norteña se incrementó un 126%. Por otra parte, el promedio de casos diarios creció un 67% en el país en los últimos 14 días.
Martes 07 de Diciembre 2021
Dosis de refuerzo: acotan su aplicación a cinco meses después del esquema completo
La ministra de Salud, Carla Vizzotti, se reunió con sus pares de todo el país para decidir los nuevos lineamientos del plan de vacunación. Pase sanitario, Ómicron y aumento de inoculaciones en la última semana fueron otros de los temas que se trataron.
Lunes 06 de Diciembre 2021
Para el doctor López Rosetti, el Covid-19 "se convertirá en una enfermedad de no vacunados"
El especialista señaló que el virus en el futuro estará presente de "manera local y en pequeños focos" pero que, para eso, es fundamental que toda la sociedad se vacune.
Domingo 05 de Diciembre 2021
Cuáles son los síntomas de la variante Ómicron de coronavirus
A pesar de la alta transmisibilidad del linaje, que ya se encuentra en la Argentina, los efectos que provoca en la salud del paciente son leves en los casos evaluados hasta el momento
Domingo 05 de Diciembre 2021
"Pase sanitario" en todo el país
La ministra de Salud, Carla Vizzotti, anunció que el pase sanitario funcionará para "alentar la vacunación en la población"
Domingo 05 de Diciembre 2021
Cannabis: crecen los proyectos en Santa Fe que apuestan a innovar en esta industria
En Santa Fe surgen desarrollos para potenciar la producción y uso de cáñamo y el cannabis medicinal. Los pasos en Argentina para regular a la industria
Viernes 03 de Diciembre 2021
La OMS no registra hasta el momento ninguna muerte por cepa Ómicron
Desde que las autoridades sudafricanas alertaron al mundo de su descubrimiento, el 24 de noviembre, se han registrado casos de covid debidos a esa variante en unos 30 países en todos los continentes.
Viernes 03 de Diciembre 2021
¿Por qué solo 13 países en el mundo vacunan a los menores de 12 años?
Europa aún no inició la inmunización pediátrica, pero los expertos coinciden en que tarde o temprano se hará efectiva; diferentes estrategias sanitarias de los gobiernos frente a esta población
Viernes 03 de Diciembre 2021
El largo y complejo viaje de los 250 millones de “vacunas latinoamericanas” de AstraZeneca
El ambicioso acuerdo entre el sector privado y los Gobiernos de México y Argentina apenas rebasa los 70 millones de dosis terminadas, menos de la mitad de lo que se prometió, aunque los socios defienden que hay razones para el optimismo
Martes 30 de Noviembre 2021
Síntomas de Ómicron: dolor muscular, fatiga y cefalea, pero sin pérdida del gusto ni el olfato
Pese a que la la Ciencia sostiene que áun tenemos más dudas que certezas, se confirma que la variante es más contagiosa que las anteriores.
Martes 30 de Noviembre 2021
Variante Ómicron: Sputnik V y Pfizer ya trabajan en nuevas versiones de sus vacunas
Según el Fondo Ruso de Inversión Directa, varios cientos de millones de dosis de la nueva versión de Sputnik podrían estar disponibles para febrero de 2022. Por su parte, Pfizer ya realizó su primer modelo de ADN, que es la primera etapa del desarrollo de una nueva vacuna.
Lunes 29 de Noviembre 2021
Pfizer, Gamaleya y Moderna ya trabajan en vacunas contra la variante Ómicron
Los científicos de los tres laboratorios confían en que las fórmulas de las vacunas actuales serán efectivas para la nueva mutación, pero ya analizan las posibilidades de crear un nuevo suero en caso de que no lo sean.
Lunes 29 de Noviembre 2021
“No sé si Pfizer es mejor que Coronavac para vacunar a niños”, dijo el pediatra Gustavo Giachetto
El catedrático grado 5 de pediatría cree que es “necesario” tener matices con respecto a la vacunación porque “no todo es blanco o negro”.
Lunes 29 de Noviembre 2021
Variante ómicron del coronavirus: ¿Los síntomas son más graves? ¿Están protegidos los vacunados?
Qué sabemos de la nueva variante ómicron del coronavirus: según los expertos, es probable que la protección de las vacunas en los casos más graves siga siendo alta
Lunes 29 de Noviembre 2021
Siete millones de argentinos todavía no recibieron la segunda dosis de la vacuna
Lo reconoció la ministra de Salud, quien sin embargo aclaró que todos recibieron la convocatoria para ser vacunados.
Lunes 29 de Noviembre 2021
Moderna evalúa el hipotético desarrollo de una vacuna contra la variante Ómicron del COVID-19 para 2022
Desde que la nueva cepa fue identificada a mediados de la semana pasada, los principales fabricantes de inmunizantes en occidente, entre ellos los estadounidenses Pfizer y Johnson & Johnson, empezaron a probar la efectividad de sus productos contra la nueva mutación del virus
Viernes 26 de Noviembre 2021
B.1.1.529: por qué causa preocupación la variante del coronavirus altamente mutada hallada en Sudáfrica
Estamos de vuelta en un territorio familiar: una preocupación creciente por una nueva variante del coronavirus.
Jueves 25 de Noviembre 2021
Nueva y peligrosa variante del coronavirus hallada en Botsuana
Científicos internacionales confirmaron que tiene una alta combinación de mutaciones. Podría generar más contagios al evadir las defensas del cuerpo. Hasta ahora fue detectada en tres países
Jueves 25 de Noviembre 2021
El regulador europeo aprobó la vacuna de Pfizer contra el coronavirus para niños de entre 5 y 11 años
El continente se suma así a Estados Unidos que recientemente autorizó el preparado para el mismo grupo etario
Jueves 25 de Noviembre 2021
La eficacia de las vacunas de Pfizer desciende a partir de los 90 días: el riesgo de infección es casi 3 veces mayor a los 5 meses
Un gran estudio realizado en Israel en más de 80.000 personas vacunadas confirmó la disminución de la eficacia de la vacunación. A los seis meses, la tasa de positividad entre los vacunados es del 15,5%
Jueves 25 de Noviembre 2021
Alemania rebasó el umbral de las 100.000 muertes por COVID y sumó un nuevo récord de contagios
En las últimas 24 horas, el país registró 351 fallecimientos y 75.961 infecciones, en una cuarta ola que no da señales de frenarse. La tasa de vacunación con la pauta completa todavía no alcanza el 70 por ciento
Martes 23 de Noviembre 2021
El sombrío pronóstico de la OMS para Europa: teme otros 700.000 muertos por coronavirus hasta marzo
El organismo advirtió que si se mantuviera la actual situación epidemiológica 25 países de la región europea se arriesgan a sufrir falta de camas en hospitales
Domingo 21 de Noviembre 2021
Ciertos trastornos del sueño aumentan el riesgo de COVID-19 grave
Un estudio científico realizado en la Clínica Cleveland de Estados Unidos encontró que esas personas tienen una tasa de hospitalización y mortalidad por coronavirus 31% mayor. Los detalles del estudio
Viernes 19 de Noviembre 2021
Camino paralelo a las vacunas: un innovador cóctel de anticuerpos monoclonales de AstraZeneca mostró una reducción del 83% en el riesgo de contraer COVID-19
Dos nuevos ensayos de Fase III le permitieron a los científicos de la compañía anglosueca demostrar que la combinación de anticuerpos monoclonales de acción prolongada reduce ampliamente el riesgo de desarrollar COVID-19; tanto en la prevención al virus como en el tratamiento. En exclusiva, desde México, uno de los expertos del proyecto lo explicó a Infobae
Jueves 18 de Noviembre 2021
Descubrieron el mecanismo por el cual algunas bacterias sobreviven a los antibióticos
Una investigación liderada por una científica argentina y un estadounidense descubrió el mecanismo por el cual algunas bacterias pueden sobrevivir a los antibióticos y la respuesta inmune, un conocimiento considerado clave para el desarrollo de tratamientos específicos y la mejor aplicación de los ya existentes.
Miércoles 17 de Noviembre 2021
OPS advierte sobre excesivo uso de antibióticos en pandemia
La Organización Panamericana de la Salud advirtió el miércoles que varios países de Latinoamérica y el Caribe han hecho un uso desmedido de los antibióticos para atender a enfermos de coronavirus hospitalizados que no los necesitaban.
Miércoles 17 de Noviembre 2021
El doctor Alberto Cormillot explicó por qué aumentaron las vasectomías
El doctor Alberto Cormillot se refirió en “Cada Mañana” por Radio Mitre a la suba de estas operaciones como método anticonceptivo masculino.
Martes 16 de Noviembre 2021
Una argentina es la segunda paciente con VIH que se curó sin tratamiento
El primer caso fue una mujer californiana de 67 años que fue diagnosticada en 1992. Ahora, confirman que otra persona superó el virus sin tomar medicacion. La importancia de estudiarlas en detalle.
Martes 16 de Noviembre 2021
Pfizer acuerda que otras compañías fabriquen su píldora contra el coronavirus
La farmacéutica estadounidense Pfizer firmó un acuerdo con una organización auspiciada por la Organización de las Naciones Unidas (ONU), para permitir que otros laboratorios fabriquen su píldora experimental contra el coronavirus, lo que podría hacer disponible el tratamiento a más de la mitad de la población mundial.
Viernes 12 de Noviembre 2021
Año I del Covid: récord histórico de suicidios
El año 2020 se cierra con 3.941 muertes, una cifra jamás alcanzada desde que hay registros (1906). La pandemia activó todos los factores de riesgo de una muerte multicausal: hubo un 7,4% más de suicidios en general y el doble de niños que en 2019
Viernes 12 de Noviembre 2021
Pastillas antivirales COVID: lo que los científicos todavía quieren saber
Medicamentos como molnupiravir y Paxlovid podrían cambiar el curso de la pandemia si los resultados de los ensayos clínicos se mantienen en el mundo real.
Jueves 11 de Noviembre 2021
Tener un resfriado común brinda cierta protección contra Covid al dar a los pacientes una ventaja inicial, encuentra un estudio
Recuperarse de un resfriado podría proporcionar a algunas personas una protección adicional contra Covid.
Miércoles 10 de Noviembre 2021
Covid: identificaron la mutación de la variante delta que la vuelve tan contagiosa
A través de un innovador método, científicos estadounidenses descubrieron una alteración de la proteína N que aumenta su capacidad de replicación respecto de la versión original del coronavirus
Miércoles 10 de Noviembre 2021
La aprobación de la Sputnik V en la OMS va en "dirección positiva", dijo el gobierno ruso
La evaluación de la Organización Mundial de la Salud (OMS) para el reconocimiento de emergencia de la vacuna Sputnik V contra la Covid-19 va en "dirección positiva", declaró este miércoles el ministro de Salud ruso, Mijaíl Murashko.
Miércoles 10 de Noviembre 2021
El creador de la vacuna Sputnik V dice que el Covid-19 desaparecerá sólo si la vacunación es "obligatoria"
El director del centro Gamaleia, fabricante de la vacuna Sputnik V, afirmó que la pandemia de coronavirus sólo terminará si la vacunación se hace obligatoria, ya que los rusos siguen siendo reticentes a vacunarse a pesar de la grave ola epidémica.
Miércoles 10 de Noviembre 2021
Alemania registró un récord de casos de COVID-19 y algunos hospitales ya hablan de situación crítica
El país reportó casi 40 mil nuevos contagios en las últimas 24 horas. Advierten que la vacunación debe acelerarse urgentemente.
Martes 09 de Noviembre 2021
La vacuna de Pfizer mostró 91% de eficacia en niños de 5 a 11 años, según un nuevo estudio
Un ensayo realizado con la vacuna contra el COVID-19 del laboratorio Pfizer en niños de 5 a 11 años detectó una alta eficacia, estimada en 91%, además de una respuesta inmune fuerte y nulos efectos secundarios graves.
Martes 09 de Noviembre 2021
Los mayores de 50 años que tuvieron COVID-19 mostraron mayor inmunidad que los más jóvenes
Con la aparición de nuevas variantes del SARS-CoV-2 en todo el mundo, y la reticencia a la vacunación entre las poblaciones de países como Alemania, Francia y Estados Unidos, la suba de contagios empieza a acelerarse en varias zonas de Europa.
Martes 09 de Noviembre 2021
BioNTech ganó 7.123 millones de euros en los primeros nueve meses de 2021
El laboratorio alemán BioNTech , responsable junto al estadounidense Pfizer de una de las vacunas de ARN mensajero contra el Covid-19 que se administran de forma masiva en el mundo, obtuvo un beneficio neto de 7.126,3 millones de euros en los primeros nueve meses de 2021, frente a las pérdidas de 351,7 millones de euros de un año antes, informó hoy la compañía.
Lunes 08 de Noviembre 2021
Un estudio realizado en Argentina probó que combinar Sputnik V y Moderna triplica los anticuerpos en mayores de 60 años
Un estudio realizado en la provincia de Santa Fe demostró que las personas mayores de 60 años que recibieron la primera dosis de la vacuna Suptnik V y completaron su esquema con Moderna obtuvieron el triple de nivel de anticuerpos que aquellas que fueron inoculadas con la misma droga.
Lunes 08 de Noviembre 2021
Vacunas COVID: la tercera dosis tiene efectos secundarios más leves que la primera
El 41% de la humanidad ya tiene el esquema completo de vacunación contra el COVID-19.
Viernes 05 de Noviembre 2021
Covaxin: por qué la vacuna india podría ser clave en el combate contra la pandemia
La Organización Mundial de la Salud otorgó el miércoles 3 de noviembre la autorización para su uso de emergencia de la vacuna contra el COVID-19 Covaxin, fabricada en India con lo que sumó una nueva herramienta a la lucha contra el coronavirus que causó la actual pandemia.
Viernes 05 de Noviembre 2021
Coronavirus: cuántas dosis de la vacuna serán necesarias, según Marta Cohen
La patóloga y pediatra de La Plata que reside en el Reino Unido, analizó la situación epidemiológica y planteó estrategias en materia de vacunación
Viernes 05 de Noviembre 2021
Pfizer anunció que su píldora contra el coronavirus redujo el riesgo de hospitalización y muerte en un 89%
Se trata de la segunda pastilla antiviral que demuestra una gran eficacia para tratar el COVID-19. El laboratorio enviará los datos de su desarrollo al FDA para lograr la autorización en EEUU cuanto antes
Jueves 04 de Noviembre 2021
Cuáles son las 7 vacunas avaladas por la OMS y cuáles están en lista de espera
En el mundo, ya diferentes vacunas contra el COVID-19 autorizadas por organismos regulatorios de inmunizaciones y medicamentos en los países.
Jueves 04 de Noviembre 2021
COVID-19: un estudio determinó cuán posible es contagiarse jugando al fútbol
Al detectar jugadores con coronavirus, los investigadores determinaron en qué porcentaje podrían haberse infectado dentro de la cancha.
Miércoles 03 de Noviembre 2021
Qué refuerzo es más efectivo dependiendo si se recibió la vacuna Moderna, Pfizer o Johnson & Johnson
¿Es mejor recibir un refuerzo del mismo componente o mezclar y combinar? Un nuevo estudio de National Institutes of Health (NIH) demostró que recibir una vacuna diferente a la inicial aumenta los niveles de anticuerpos en los receptores de las vacunas Moderna, Pfizer o Johnson & Johnson.
Miércoles 03 de Noviembre 2021
La OMS aprobó el uso de emergencia de la vacuna india Covaxin contra el coronavirus
La Organización Mundial de la Salud autorizó el miércoles el uso de emergencia a una vacuna contra el COVID-19 desarrollada en India, lo que avala a un fármaco que los reguladores del país autorizaron mucho antes de completar las pruebas avanzadas de inocuidad y eficiencia.
Miércoles 03 de Noviembre 2021
La vacuna Sputnik Light es segura y genera una fuerte respuesta inmune contra el COVID-19, según The Lancet
La vacuna monodosis rusa Sputnik Light tiene un alto perfil de seguridad y genera una fuerte respuesta inmune celular y humoral contra el coronavirus.
Martes 02 de Noviembre 2021
Pfizer anunció que su medicamento oral contra el COVID-19 podría estar disponible este año
La compañía, que desarrolló la primera vacuna contra el virus, afirmó que espera los resultados definitivos de estudios que han mostrado señales alentadoras y la autorización de los entes sanitarios
Lunes 01 de Noviembre 2021
Preguntas de la audiencia sobre el coronavirus: ¿Puede una persona infectarse de covid-19 dos veces en un mes?
Esta semana, el doctor Elmer Huerta responde algunas dudas de nuestra audiencia sobre los efectos secundarios de las vacunas contra el covid-19: desde posibles ronchas en la piel hasta la pérdida del cabello.
Lunes 01 de Noviembre 2021
Vacunas de ARN mensajero contra el COVID-19: un viaje al corazón de la tecnología y la innovación argentina
La Organización Mundial de la Salud eligió a una empresa de nuestro país para producir estos sueros. TN recorrió las plantas: procesos, tiempos y un futuro que ya se presenta como prometedor.
Sábado 30 de Octubre 2021
Dura advertencia de la OMS sobre un posible virus que "no seremos capaces de contener"
El director general de la entidad pidió tomar las lecciones de la pandemia de coronavirus que aún está en curso para estar preparados para la próxima
Viernes 29 de Octubre 2021
Vacunarse no evita que las personas propaguen la variante Delta, según un nuevo estudio
Las personas con dos dosis de la vacuna contra el coronavirus tienen la misma probabilidad de transmitir la variante delta del virus a contactos en su hogar que aquellas que no han recibido vacunas, según "The Lancet".
Jueves 28 de Octubre 2021
"Será imposible saber cuál fue el origen del coronavirus", advirtió la creadora de una vacuna contra el COVID-19
Pasó de ser una profesora de vacunología en la Universidad de Oxford desconocida para la mayor parte de la sociedad al “cerebro” detrás del desarrollo de la vacuna para prevenir el COVID-19 del laboratorio AstraZeneca.
Jueves 28 de Octubre 2021
La OMS advierte de que Europa registra la mayor subida de nuevos casos de Covid-19
Reino Unido, Rusia, Turquía o Ucrania destacan por sus nuevas oleadas de contagios de coronavirus
Jueves 28 de Octubre 2021
El virus sincitial se ceba con los recién nacidos en Italia: ¿cuáles son su síntomas?
En Italia una epidemia de virus respiratorio sincitial entre los recién nacidos ha hecho saltar todas las alertas. ¿Por qué hay tantos casos ahora?
Miércoles 27 de Octubre 2021
COVID-19: incluso quienes reciban la tercera dosis, serán convocados para los refuerzos de vacunación
El subsecretario de Estrategias Sanitarias del Ministerio de Salud de la Nación, Juan Manuel Castelli, dijo hoy que todas las personas serán convocadas en los próximos meses para aplicarse dosis de refuerzo de las vacunas contra el COVID-19, incluidas aquellas que deben recibir una tercera dosis, según anunciaron ayer las autoridades sanitarias, que incluye a los mayores de 50 años con el esquema completo del inoculante Sinopharm y los mayores de 3 años inmunocomprometidos que hayan recibido cualquiera de los fármacos.
Miércoles 27 de Octubre 2021
Los CDC dicen que algunas personas inmunodeprimidas pueden recibir una cuarta vacuna contra el coronavirus
Los Centros para el Control y la Prevención de Enfermedades dicen que algunas personas con sistemas inmunitarios debilitados que recibieron la vacuna contra el coronavirus de Moderna o Pfizer-BioNTech pueden recibir una cuarta inyección.
Miércoles 27 de Octubre 2021
Las vacunas de la covid podrían ayudar a mejorar las vacunas contra la influenza
Los fabricantes apuestan a que la tecnología de ARNm que impulsa dos exitosas vacunas para la covid ayudará a frenar el trágico número de muertes que la gripe provoca en todo el mundo.
Martes 26 de Octubre 2021
¿Es gripe o COVID-19?: 5 principales diferencias que distinguen hoy a esas infecciones
La gripe y el COVID-19 son hoy dos infecciones respiratorias y virales cuyos casos más graves son prevenibles a través de la vacunación.
Martes 26 de Octubre 2021
Para la OMS, el mundo aún no aprendió sobre el Covid-19
Un año y medio después del estallido de la pandemia de Covid-19, el mundo sigue dando una respuesta insuficiente y no aprende de sus errores, advirtió el martes un organismo independiente creado por la Organización Mundial de la Salud (OMS) y el Banco Mundial.
Lunes 25 de Octubre 2021
Por qué noviembre será un mes clave para la pandemia en la Argentina, según la mirada de Conrado Estol
El reconocido neurólogo Conrado Estol se refirió al avance de la vacunación en la Argentina: ”Ya tenemos el 56% de la población con dos dosis, lo cual es bueno porque se aceleró el ritmo desde las PASO, que había caído muchísimo la aplicación diaria, con esta velocidad el 11 de noviembre vamos a tener 70% de la población vacunada. Pero eso no es suficiente para amortiguar significativamente un eventual rebrote de Delta si no se dan refuerzos”.
Lunes 25 de Octubre 2021
Covid-19: Moderna confirma "seguridad y eficacia" de su vacuna en niños de 6 a 11 años
La compañía norteamericana Moderna informó hoy que su vacuna contra el coronavirus generó una "sólida respuesta de anticuerpos neutralizantes" en la población de 6 a 11 años.
Viernes 22 de Octubre 2021
La mirada de la experta Marta Cohen sobre el avance de los casos de COVID-19 en la Argentina
La reconocida patóloga argentina Marta Cohen, radicada en el Reino Unido hace 18 años, analizó el rebrote de casos de COVID-19 que está sufriendo Gran Bretaña y realizó una comparación con lo que puede suceder en el futuro en la Argentina y la región.
Viernes 22 de Octubre 2021
Pfizer anunció que su vacuna contra el coronavirus tiene una eficacia superior al 90% en niños de 5 a 11 años
Las dosis menores de la vacuna contra el coronavirus de Pfizer parecen seguras y presentan una eficacia de casi el 91% en la prevención de infecciones sintomáticas en niños de 5 a 11 años, según los detalles de un estudio de la compañía publicado este viernes, mientras Estados Unidos estudia la posibilidad de abrir la inmunización a ese grupo de edad.
Viernes 22 de Octubre 2021
La ANMAT prohibió una marca de miel, un aceite de girasol y un producto médico
Esta madrugada la Administración Nacional de Medicamentos, Alimentos y Tecnología Médica (ANMAT) prohibió la comercialización de un producto médico, un aceite de girasol y una miel orgánica por inconvenientes en sus inscripciones y registros.
Viernes 22 de Octubre 2021
Delta plus: la nueva mutación del coronavirus que está causando un número creciente de infecciones en Reino Unido
Las autoridades sanitarias de Reino Unido están vigilando detalladamente una nueva mutación de la variante delta del coronavirus que está causando un incremento en los casos de covid.
Jueves 21 de Octubre 2021
Encuentran virus en murciélagos similares al de Covid-19
Mientras aún, a nivel mundial, persiste la duda sobre cómo se originó el coronavirus, la actual pandemia, se dieron a conocer más detalles sobre el hallazgo de tres virus en murciélagos de Laos que son más similares al SARS-CoV-2 que cualquier otro conocido.
Jueves 21 de Octubre 2021
Covid-19: Pfizer y BioNTech informan alta eficacia de dosis de refuerzo
Pfizer Inc y su socio alemán BioNTech SE informaron el jueves que datos de un ensayo de fase III demostraron una alta eficacia de una dosis de refuerzo de su vacuna Covid-19 contra el virus, incluido la variante Delta.
Jueves 21 de Octubre 2021
La Unión Europea no aprobaría la vacuna Sputnik V antes de 2022
La Agencia Europea del Medicamento solicitó un expediente más completo sobre la producción, para saber dónde solicitar las inspecciones. Si los datos se presentan en las próximas semanas, la eventual aprobación recién se daría el año próximo
Jueves 21 de Octubre 2021
EEUU: la FDA aprobó las dosis de refuerzo de Moderna y Johnson & Johnson y habilitó la combinación de vacunas
Las decisiones de la Administración de Alimentos y Medicamentos suponen un gran paso hacia la ampliación de la campaña de refuerzo en el país norteamericano, que comenzó con dosis adicionales de la vacuna de Pfizer el mes pasado
Miércoles 20 de Octubre 2021
Recibir la vacuna contra el COVID-19 puede aumentar la protección contra diferentes coronavirus
En el mundo se han descripto 45 especies de coronavirus. El primero se encontró en 1965, pero estos virus se han vuelto populares por la pandemia que provocó el coronavirus SARS-COV-2 a partir de diciembre de 2019, y hay miles de investigadores intentando comprender la enfermedad, sus secuelas y las vacunas que ya han demostrado alta eficacia y seguridad.
Martes 19 de Octubre 2021
La FDA planea permitir la combinación de varias vacunas como refuerzo contra el covid-19, afirman fuentes
La Administración de Alimentos y Medicamentos de EE.UU. (FDA, por sus siglas en inglés) planea permitir que los estadounidenses reciban una vacuna diferente a su vacuna original contra el coronavirus para sus dosis de refuerzo, según dos fuentes familiarizadas con el pensamiento actual dentro de la agencia.
Martes 19 de Octubre 2021
Unicef pidió por el Etiquetado Frontal de Alimentos
El Fondo de las Naciones Unidas para la Infancia (Unicef) aseguró hoy que el proyecto de Ley de Etiquetado Frontal que fue aprobado por el Senado y aguarda ser tratado en la Cámara de Diputados "beneficia a toda la sociedad argentina y especialmente a las familias más vulnerables", por lo que es un mito que sea una "ley para personas ricas".
Lunes 18 de Octubre 2021
"Va a estar dentro de nuestra capacidad" prevenir otro aumento de covid-19, dice Fauci
El giro optimista en el número de casos de covid-19, hospitalizaciones y muertes podría terminar en otro pico de infecciones, dijo el domingo el Dr. Anthony Fauci. Pero EE.UU. aún podría prevenir ese aumento con tasas de vacunación más altas.
Lunes 18 de Octubre 2021
Cuáles son los riesgos en las embarazadas con COVID-19 que presentan síntomas
Con el avance de la pandemia por el coronavirus por el mundo, la investigación científica está desentrañando cuál es el impacto que la infección está produciendo en diferentes grupos de la humanidad.
Lunes 18 de Octubre 2021
La Anmat prohibió unas ampollas antiarrugas
La Administración Nacional de Medicamentos y Tecnología Médica (Anmat) prohibió el uso y la comercialización en todo el territorio nacional de todos los lotes de unas ampollas importadas utilizadas en tratamientos antiarrugas.
Viernes 15 de Octubre 2021
Adultos no vacunados enfrentan un riesgo 11 veces mayor de morir por covid-19 que los vacunados, según los CDC
Los adultos no vacunados en Estados Unidos enfrentan un riesgo 11 veces mayor de morir por covid-19 que las personas completamente vacunadas.
Viernes 15 de Octubre 2021
La mitad de los recuperados de coronavirus pueden tener COVID persistente por más de 6 meses
Más de la mitad de los 239 millones de personas diagnosticadas por COVID-19 en todo el mundo podría experimentar síntomas post-COVID, también llamado COVID largo o COVID persistente, hasta seis meses después de recuperarse.
Viernes 15 de Octubre 2021
Asesores de la FDA recomendaron que todos los mayores de 18 años reciban una dosis de refuerzo de la vacuna de Johnson&Johnson
Asesores externos de la Administración de Alimentos y Medicamentos de EEUU (FDA, por sus siglas en inglés) votaron este viernes por unanimidad a favor de recomendar a los reguladores que autoricen una segunda inyección de refuerzo de la vacuna COVID-19 de Johnson & Johnson para proteger mejor a los estadounidenses que recibieron esa vacuna de una sola dosis.
Jueves 14 de Octubre 2021
Qué dice el primer estudio preliminar sobre combinación de vacunas contra el COVID-19 hecho en la Argentina
Hay que decir que para el caso argentino la estrategia sanitaria de vacunación combinada contra el COVID-19, incluso con dosis de diferentes plataformas (vacunación heteróloga) y en un contexto local de escasez -como el que sufrió la Argentina- fue una llave fundamental para que hoy la sociedad argentina - a lo ancho y a lo largo del país- pueda haber perforado el 52% de vacunados con el esquema completo (dos dosis).
Jueves 14 de Octubre 2021
Molnupiravir, el antiviral oral contra el COVID-19 que logró reducir un 50% el riesgo en casos graves
A pocas semanas de cumplirse dos años de la aparición del coronavirus SARS-CoV-2 que produce la enfermedad COVID-19, la publicación de estudios clínicos en Fase III (MOVe-OUT) de un nuevo tratamiento oral efectivo para combatirlo genera esperanza en la comunidad científica que ve en esta droga una nueva arma para derrotar la actual pandemia.
Jueves 14 de Octubre 2021
Un panel de expertos de la FDA respalda la vacuna de refuerzo COVID-19 de Moderna para grupos de alto riesgo
Un panel asesor de la Administración de Drogas y Alimentos de los EE. UU. (FDA) aprobó este jueves la autorización de emergencia para la inyección de refuerzo de la vacuna COVID-19 de media dosis de Moderna cuando se administra al menos seis meses después de la serie de dos dosis entre personas de 65 años o más, y de 18 años de edad a 64 con alto riesgo de exposición ocupacional y COVID-19 severo.
Jueves 14 de Octubre 2021
Vacunación COVID en niños: 10 certezas bajo la mirada de una experta
En exclusiva para Infobae, Marta Cohen, la patóloga pediatra argentina radicada en Reino Unido, analiza los riesgos y beneficios de vacunar a los menores de edad
Miércoles 13 de Octubre 2021
La OMS nombra a los expertos encargados de reactivar las investigaciones sobre el origen del coronavirus
La Organización Mundial de la Salud (OMS) ha anunciado este miércoles la lista de 26 expertos seleccionados para formar el nuevo Grupo Científico Asesor sobre el Origen de Nuevos Patógenos (SAGO, por sus siglas en inglés).
Miércoles 13 de Octubre 2021
Las razones de dos eminencias de la medicina para sostener que el COVID-19 fue creado en un laboratorio
Mucho se ha hablado durante el último año y medio acerca de los orígenes del coronavirus, pero aún no se conoció una respuesta que deje satisfecha a toda la comunidad científica.